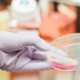
TOP ŠIHT: 8 izstopajočih prostih delovnih mest iz vse Slovenije

Komarji na Havajih niso domorodna vrsta – verjetno so jih v 19. stoletju nehote prinesle kitolovske ladje. Ker dobro uspevajo v toplih tropskih območjih, so se havajski ščinkavci dolgo časa … · Dnevnik · 4d
american bird conservancy podnebne spremembe ščinkavci biološka kontrola droni havaji ptičja malarija izumrtje vrst komarji ohranjanje narave objavi tvitaj

Nova znanstvena raziskava, objavljena v reviji Nature Communications, razkriva, da je čas uživanja hrane lahko pomembnejši dejavnik tveganja za zdravje srca kot spanec. Ugotovitve kažejo, da bi lahko preprosta sprememba … · Slovenske novice · 7M
nočna izmena zdravje zdrava prehrana nočno delo prehranjevanje raziskava objavi tvitaj

Rezultati poskusnega polletnega individualnega zbiranja odpadkov v KS Žabja vas spodbudni: 40 odstotkov manj mešanih odpadkov in 20 odstotkov več... · Lokalno.si · 1L

Mednarodna agencija za dopinška testiranja (Ita) je uvedla "strog in inteligenten" sistem za kolesarsko Dirko po Franciji. Da bi preprečila morebitno goljufanje, je Ita uvedla poseben program testiranj za francosko … · RTV Slovenija · 1L
dirka po franciji tour de france objavi tvitaj

So tudi na vaša okna priletele pikapolonice? Ob začetku hladnega in deževnega jesenskega vremena želijo drobni hroščki, ki sicer veljajo za dobre, na... · Lokalno.si · 2L

V sredo je predsednica republike in vrhovna poveljnica obrambnih sil Nataša Pirc Musar na brniškem letališču predala v uporabo nov podzemni objekt in operativno dvorano enote, ki stalno nadzoruje in … · Gorenjski glas · 2L
brnik predsednica letalisce natasa pirc musar slovenska vojska vrhovna poveljnica obrambnih si slovenija vojska objavi tvitaj
So službe. In so »top šihti«, ki jih za vaš nov začetek izbrskamo vsak teden. Tokrat smo pripravili seznam kar osmih prostih delovnih mest z različnih koncev Slovenije, vse od … · Maribor24 · 2L